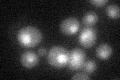
YBL032W
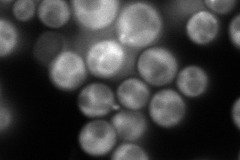
YBL032W
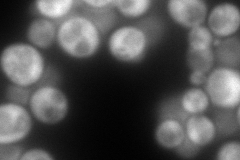
YBL032W
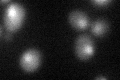
YBL032W

View description
RNA binding protein involved in the asymmetric localization of ASH1 mRNA; represses translation of ASH1 mRNA, an effect reversed by Yck1p-dependent phosphoryation; regulates telomere position effect and length; similarity to hnRNP-K
Localization:
Intensity:
Fold change:
Significance:
-
C’ GFP library in SD
nucleus24.1 -
N' NOP1pr-GFP in SD
cytosol297.965 -
N' TEF2pr-mCherry in SD
cytosol254.34 -
N' NATIVEpr-GFP in SD

cytosol,punctate,bud52.4437 -
N' TEF2pr-VC and Cyto-VN in SD

cytosol90.7712 -
C’ GFP library in SD+DTT
nucleus22.660.93No -
C’ GFP library in SD+H2O2

nucleus23.890.99No -
C’ GFP library in Starvation Media

nucleus29.731.23No -
C’ GFP library on the background of Pup2-DaMP

nucleus -
C’ GFP library on the background of CCT mutant

nucleus20.37530.844976No
